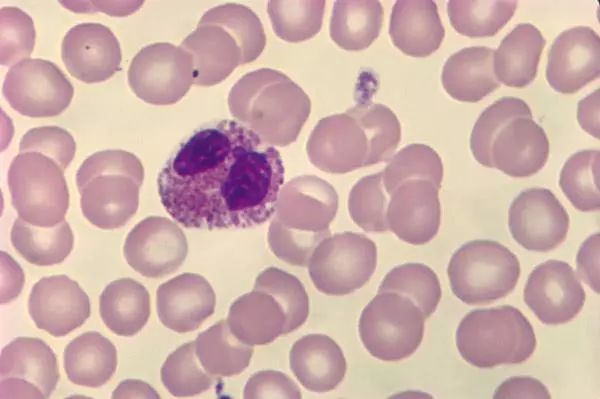
关于EGC身为铲屎官的你知多少？各种皮肤病都可能是EGC！

猫咪疾病向来棘手,想要对付这些种类繁多、病症不一的神秘猫病呢,得先行一步认识它们——知己知彼,百战不殆嘛。
大部分铲屎官可能都不知道什么是EGC,其全称叫做嗜酸性肉芽肿复合体,别看名字听起来高端,解释起来也是能通俗易懂滴。

那么本文就从以下几个方面来阐述这一看似罕见的猫病吧:
- 什么是EGC
- EGC的分类
- 诊断与病因分析
- 怎么防治EGC
嗜酸性肉芽肿是一种看似神秘的怪病_(:з」∠)_,表现在猫身上的症状各有不同。
又因为动物医学在嗜酸性肉芽肿方面的研究还不够成熟,所以猫咪碰上的话就比较麻烦。

如果大家伙们都能一起从它的定义、分类到诊断、起因及预防与治疗,来提前了解了解EGC这个疾病,对人对猫都是件好事。
什么是EGC?
嗜酸性肉芽肿是一种不太常见的猫咪皮肤炎症性疾病,根据发病部位的多处不同,被人喊做嗜酸性肉芽肿复合体( Feline eosinophilic granuloma complex,下文统称EGC),看起来也比较统一嘛。

EGC发病部位通常在猫的体表皮肤、嘴唇等位置,不具有特异性哦。
其并非是特发性的疾病,而是猫咪多个病症的反应模式如溃疡、发炎等等。
而根据发现呢,这些伤口都存在着大量的嗜酸性粒细胞,还有一些数量适中的中性粒细胞以及瘢痕组织。
后两者是啥我们别管,先搞清楚嗜酸性粒细胞,也就是EGC里的这个E(eosinophil)是什么才是最主要的任务。

嗜酸性粒细胞,是白细胞的组成部分,作为免疫系统的标兵(厉害了有木有),这些细胞来源于骨髓,然后进入血液,功能在于*伤杀**细菌与寄生虫,可是免疫反应与过敏反应过程中极为重要的细胞呢。
嗜酸性粒细胞任务完成之后呢,会融入身体组织,继续警惕着外来入侵者,等到跟其紧密联动的肥大细胞侦测到危险时,会召唤嗜酸性粒细胞出来消灭敌人。
如果肥大细胞识别出错,将一些无害物质,如食物蛋白质、跳蚤口水或者蚊子唾液看成外敌时,就会号召大量嗜酸性粒细胞出来抵御,直到局面难以控制,嗜酸性粒细胞就会六亲不认把身体组织一并杀灭,这样过度防御外现在猫身上就是过敏反应。

以上就是EGC的发病机制,而发病的猫咪有什么性别、年龄之别吗?
EGC病患一般是青年至中年的猫咪,年龄区间在2~6岁之间(均龄3.5岁),其患病率和猫咪的性别基本无关,而跟基因有关。
研究发现,喜马拉雅猫、挪威森林猫患EGC的几率较高。
得了EGC的猫咪反应也是各有不同,有些患病后没什么感觉,精神食欲都与平日无异,有些猫则会瘙痒难忍;
有的病猫出现症状之后,过段时间竟然就自愈了,而有的却怎么折腾都无所疗效。

那么猫咪一旦发病,会出现什么样的症状呢?
EGC的分类
根据病症发生部位,可以将EGC大致分为:
1.无痛性溃疡
或称嗜酸性溃疡、侵蚀性溃疡,顾名思义,这是一种皮肤、皮肤黏膜和口腔黏膜损伤。
这症状多发于上唇、单侧,但也有双侧发病的情况,嘴唇边缘会出现异常增厚、肿胀、脱毛,呈现出棕红、白黄等的颜色,严重的会发展成凹陷式溃疡,直到出血、变硬等,极大影响猫咪的外观。

口腔的病变部位在于口腔上部、舌头以及咽喉,患猫的口腔恶臭、会流口水(口水也很臭),进食和吞咽都比较困难。
2.嗜酸性斑块
这是一种皮肤性损伤,会在猫咪皮肤的任何部位发病,多见于下腹及后腿(大腿内侧),脖子、颈部和肛周也比较容易发生,出现的是圆形、椭圆形或者条形的脓疮(突起)及溃疡,颜色呈浅粉色(红斑),猫咪容易瘙痒抓挠,从而出现脱毛、红肿、渗液乃至溃疡。
3.粒性皮肤炎
如果是皮炎的话,叫做粒性皮肤炎,可能出现脱毛,或者一粒粒红肿的小包。

要知道,猫咪体表EGC与皮炎都与跳蚤脱不了干系,尤其是在广东福建海南等等南方地区的猫咪。
居住在蚊虫跳蚤多发地的铲屎官,应当看到适时给猫咪进行体内外驱虫的重要性。
4.嗜酸性肉芽肿
或称线性肉芽肿、溶胶原性肉芽肿,发病于大腿后侧、脸部和口腔,尤其是舌和腭,也会出现在足部、爪子上。
爪子得EGC的猫其爪子或爪垫会红肿、发炎(气味不可描述),甚至可能出现裂纹,所以走路可能一瘸一拐。

脸部得EGC的猫,鼻子上会出现奇怪的红肿、脱毛;
如果是眼部EGC,则被称作嗜酸性粒细胞性角膜炎,多数只会在一只眼睛上发病,能观察到外侧透明角膜上出现琥珀色,有时掺杂灰色或者粉色的、粗糙微凸的组织。
口腔病变能看到表面出现的糜烂或溃疡,上面具有明显的白色斑块,病猫一样会吞咽困难以及难以进食。

值得注意的是,眼部毛病是否为EGC还有待讨论,而另一具有争议性的是肠道EGC:嗜酸性粒细胞性肠炎(Eosinophilic enteritis),简称EE。
5.嗜酸性粒细胞性肠炎(EE)
这种病变表现为胃部及肠道内壁出现某些炎症性反应,猫咪容易呕吐、腹泻、食欲不振而随之体重下降——是不是有点眼熟,与猫炎症性肠炎IBD有点类似吧?
但EE与猫IBD是不能划等号滴(^з^)-☆。

IBD是猫咪慢性消化系统疾病的统称,会包括EE,但EE却并不常见。
如果要做区分,得利用肠道取样进行组织活检,难度较大。
组织活检固然是一种精确的诊断方法,与一些其他较为简易的诊断方法并用,才能给出全面的诊断结果。
诊断与病因分析
最平易近人的诊断方式当然就是根据临床表现观察症状啦,按照上面几种症状分类可以轻易判断出体表EGC以及嘴唇EGC。

其他情况下的EGC就需要利用精准确定的诊断方式来辨别:
1.首先要做血常规,助于观察嗜酸性粒细胞的指标是否正常,如果细胞数量异常庞大则要引起注意。
2.接着便是给猫做生化,用以排除其他可能的类似疾病。
3.如需再作进一步的精确诊断,就是活体组织检查啦:取下病变的一小块组织,看看组织中是否包含了大量的嗜酸性粒细胞,从而确定其是否是EGC。
然而单单看嗜酸性粒细胞的数量还不够,因为个别病猫的肥大细胞数量比前者还多,这种情况仍然要算作EGC,所以还得检查肥大细胞。
当然,如果在病变组织中找不到大量(超过正常数量)的嗜酸性粒细胞和肥大细胞的话,就可以排除掉EGC啦,要考虑的原因可能就是真菌感染、肿瘤或者异物导致的外伤等等这些情况咯。

不过,假使要给上述的病症情况做诊断,具体还可以这么分:
a.对于猫无痛性溃疡来说,组织检查并不具有诊断性,可以排除皮肤恶性肿瘤的还需组织活检,皮肤恶性肿瘤在血液里很少能检查到嗜酸性细胞。
b.如果是猫嗜酸性斑块,通常能在细胞膜片上见到嗜酸性粒细胞,如果是继发性感染,则可以看到更多的中性粒细胞以及细菌;
这情况一般来说能产生各种各样的组织活检结果,在外周血液中可见嗜酸性粒细胞增多,而表皮层会出现弥散性的棘细胞层水肿(组织病理学专有名词不用太在意哦),另外还能发现火焰状图形。

c.嗜酸性肉芽肿,与第二种情况的前者相类似;
另外,嗜酸性肉芽肿还具有典型的组织细胞、嗜酸性粒细胞和多核巨细胞合并胶原变性的病灶点(就是一种病变啦),使用异染性染剂时,能观察到巨细胞增生(如图);

在口腔发生病变时,嗜酸性粒细胞可能存在于血液中,因而这种慢性病变就很少能检测到大量的嗜酸性粒细胞啦。
以上便是诊断EGC的详细介绍,接下去就要探寻EGC可能的起因,可以分成这几个因素:
△跳蚤
跳蚤及其唾液能使猫出现敏感的反应,这些猫被跳蚤叮咬要么会爆发EGC,要么会得过敏性皮炎。

而且,最新科研成果发现:
寄生虫叮咬本身不会导致过敏,但被叮咬后,你会突然对其他东西过敏。
据此有人推断,猫咪的食物过敏可能就是由这些寄生虫携带的有害菌触发的,然而真实情况到底是怎样我们就不知道啦。
猫咪体表寄生虫能引起皮肤病变,自然不只有跳蚤一种啦,还有虱子、蠕形螨等等的其他寄生虫祸害呢。
△食物过敏
许多兽医认为:
食物过敏是猫咪粒性皮肤炎的罪魁祸首。
猫咪行为表现为吃东西会呕吐、腹泻,还会出现皮疹,使猫抓挠瘙痒,这种表现首先要考虑的可能病因是食物过敏。

△环境问题
猫咪平日的餐具、药品以及各种清洁用具都是可能导致猫咪过敏的一大因素。
△吸入性过敏
在一些过敏原中,尘螨、霉菌、花粉都可能使得猫咪产生过敏反应。
△免疫系统病变(存疑)
有研究指出,罹患EGC的猫咪体内的免疫细胞意外出错,会攻击自己的皮肤、口水。
但相关研究并未给出结果,来判定究竟是EGC导致这些抗体出现,还是这些抗体产生了EGC。

△相关病毒
相关研究表明,猫杯状病毒(FCV)以及猫艾滋病毒(FIV)不是EGC的诱发因素,如果你的病猫嘴巴、口腔出现慢性炎症乃至溃疡,除了要注意区分猫杯状病毒,还要进行猫艾滋的筛查。
一些研究认为猫疱(pao第四声哦)疹病毒与EGC,尤其是眼部EGC有关联,但疱疹病毒跟猫咪身上奇怪的皮肤病是否有关,没人知道。
这几点病因都可能引致猫咪患上EGC,知道原因才好对其进行预防,对猫咪进行治疗。

怎么防治EGC
想要治疗EGC,铲屎官需要极大的耐心,坚持到底才能get一只更加健康的猫猫哦。
☆治疗
激素类药物具有副作用这人尽皆知,但注意剂量、合理使用的话对猫咪来说不会产生特别大的伤害,主要还是看铲屎官的谨慎用药啦。
首先是口服式的甲泼尼龙,或叫长效地塞米松,能够一定程度上控制EGC;再或是曲西安龙,也能选作治疗EGC的药物。

另有一些外用的激素类药物*剂喷**、药膏等等,患有体表EGC或者粒性皮肤炎的病猫,尤其可以尝试氯地米松及抗生素*剂喷**,虽容易被猫咪舔掉,但据称效果还行,可以试一试哦。
这些药物都需要在医生的指导下严格使用,口服激素药物不是每天都可以吃的,打过长效针的猫咪需要一定的休药期(前后7天),这期间要严密监控并对可能的副作用进行定期检查,这一步对猫咪身体健康十分重要。

激素药物会削弱猫咪的免疫系统,因而在免疫系统功能减弱时还有其他药物可以考虑——yesyes,一些抗生素在治疗EGC方面具有一定的效果。
首推阿莫西林克拉维酸合剂以及多西环素,控制细菌之外,多西环素还能控制过敏反应(注意喂了多西环素之后要马上让猫咪进食进水)。
其他可供使用的药物还有孕酮类药物如甲孕酮、甲地孕酮,以及环孢素、瘤可宁等等,要结合医生的叮嘱合理选用哦。

☆防治
前面说过的第一点病因即是跳蚤,因而需要消除跳蚤才能有效预防EGC。
1.消除跳蚤以绝后患
建议铲屎官不仅要每个月(不严重的两三个月)给猫咪进行体外驱虫;
还要将门窗紧闭(装纱窗),防止猫咪外出。
这样才能全力消除跳蚤隐患。
2.多样化饮食
给猫咪更换各种不同的饮食,是预防EGC的绝佳方法哦。

有时间的铲屎官可以花点精力跟时间做自制熟肉,当然,为了避免没必要的过敏(不清楚过敏源的话),在制作早期就不要一下子添加过多的补充营养素,可以慢慢排查过敏源再一一添加。
需要注意的是,假如猫咪没有吃过生骨肉,就不要在更替饮食的过程中尝试喂食,得了EGC的猫咪其免疫系统没法像正常的猫咪那样抵御生骨肉上面的细菌。
如果习惯了平时给猫咪吃干粮,可以尝试一下希尔斯处方粮(不推荐)。

3.更替猫咪用品或搬家
搬家是相对激进的解决办法,如果猫咪身上的症状不严重,那么就可以选择更替猫咪用品。
尤其要引起关注的是猫餐具、猫窝、猫厕所(包括猫砂)、猫用药品以及一些家庭清洁用具,这些东西很可能是猫咪过敏的诱因,最好慢慢进行更换。
当然,猫饭盆以及水盆最好换成陶瓷、玻璃以及不锈钢制品。
综上所述,EGC嗜酸性肉芽肿是一种相较少见的猫咪皮肤炎症,猫咪身上的任何部位都可能遭殃,而一般多发于猫皮肤、口唇,症状不一,需要铲屎官多加注意。

这样的疾病可能不会引起猫咪多大的反应,也可能极大地影响猫咪的精神食欲,病因多样,若要排除还是需要送医检查。
而无论如何,勤奋做好日常清洁(必要的话定期更换猫咪用品),给猫提供良好的生活环境;
在猫咪饮食上多下功夫,提高猫咪身体免疫力;
定期驱虫,尽己所能杜绝跳蚤隐患……
等等这些都是铲屎官们基本要做到的。
平时也要好好把握猫咪身体状况,排查猫咪的过敏源,全力预防EGC。
最后就祝愿每一只毛孩都能健健康康,少生病吃嘛嘛香~~

本文为戒猫组长原创作品,我是家有十只猫咪的闹闹,欢迎点赞加关注哦~~
#好好宠它#